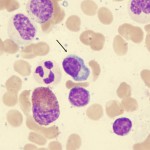

A. Explorations sanguines systématiques
- Electrophorèse des protides, Immunofixation, dosage pondéral des Ig
En cas de suspicion de cryoglobulinémie, les prélèvements doivent être transportés au chaud (cela évite une sous-estimation du pic d’IgM)
L’électrophorèse doit être idéalement surveillée dans le même laboratoire.
Pas de chaînes légères libres en routine.
Les IgA et les IgG peuvent être légèrement diminuées expliquant des problèmes récurrents d’infections ORL ou bronchiques. Leur niveau revient rarement à la normale même à distance des traitements chez les patients en rémission complète.
- NFS + réticulocytes
- +/- marqueurs d’hémolyse : Haptoglobine, Bilirubine T/C, LDH
VGM + réticulocytes afin de dépister une hémolyse sous-jacente
- Fonction rénale : créatininémie (étiologies des insuffisances rénales : cf tableau 2)
- Bilan hépatique : ASAT, ALAT, GGT, PAlc, TP
- Beta2 microglobuline, Albuminémie (intérêt pronostic)
B. Examens selon signes d’orientation
- Si anémie :
- AHAI : recherche d’agglutinines froides, Coombs
- Carence en Fer : ferritinémie +/- bilan martial complet
La carence en fer est souvent négligée. Elle est également très souvent résistante au fer per os mais pas au FER par VOIE INTRAVEINEUSE - Hémodilution
- Envahissement médullaire
- Si suspicion d’hyperviscosité ou pic monoclonal important (protidémie > 100 g/L ou pic > 30 g/L) :
- FOND D’OEIL +++: signes d’hyperviscosité (hémorragies, courant granuleux…)
Systématique si Pic > 30 g/L - Signes d’hyperviscosité + Pic d’IgM peu élevé = Rechercher une cryoglobulinémie
- FOND D’OEIL +++: signes d’hyperviscosité (hémorragies, courant granuleux…)
- Neuropathie périphérique : 20 à 25 % des patients !
- Amylose ? Cryoglobulinémie ?
- Neuropathie lié au pic IgM ?
- IgM anti MAG, Ac anti ganglioside M1 et Ac anti sulfatide
(leur absence n’exclue pas le diagnostic : cible antigénique non encore identifiée) - EMG (neuropathie démyélénisante)
- Cryoglobulinémie
- IgM anti MAG, Ac anti ganglioside M1 et Ac anti sulfatide
La biopsie nerveuse doit être évitée en raison des fréquentes complications
Plus rare : une myopathie associée à une maladie de Waldenström ? recherche d’anticorps IgM antidecorin
Tableau : Etiologies des complications neurologiques, rénales et de l’anémie dans la maladie de Waldenström
| Neuropathie | Insuffisance rénale | Anémie |
| Cryoglobulinémie | Cryoglobulinémie | Anémie hémolytique auto-immune (AHAI)
|
| Amylose | Amylose | Carence en fer |
| Neuropathie auto-immune | Dépôts d’Ig | Hémodilution (pic élevé) |
| Infiltration lymphomateuse rénale | Centrale : infiltration médullaire |
—
C. Explorations médullaire
—
Infiltration médullaire quasi-constante
Diagnostic confirmé par la mise en évidence d’une infiltration médullaire par une population cellulaire lymphoplasmocytaire composée de petits lymphocytes présentant des signes de différenciation lymphoplasmocytaire.
—
Petits lymphocytes avec différenciation plasmacytoïde/plasmocytaire(flèches)
L’infiltration médullaire peut être diffuse, interstitielle ou nodulaire et est habituellement intertrabéculaire (une infiltration uniquement paratrabéculaire doit faire évoquer le diagnostic différentiel de lymphome folliculaire).
L’infiltration médullaire doit être étayée par des explorations phénotypiques (cytométrie de flux ou immunohistochimies).
Phénotype classique : sIgM+ CD19+ CD20+ CD22+ CD79+
Classiquement : CD10-, CD23-, CD138-, CD38 low ou (-).
Jusqu’à 20 % des cas peuvent exprimer CD5, CD10 ou CD23 (diagnostic différentiel : LLC, lymphome du manteau).
Une augmentation du nombre de mastocytes associés à l’infiltrat lymphoïde est communément retrouvé dans la maladie de Waldenström à la différence d’autres lymphopathies B.
D. Cytogénétique
Délétions 6q (jusqu’à 50 % des cas) – Pas d’intérêt pronostic
La cytogénétique n’a pas d’intérêt en routine actuellement sauf pour différencier la maladie de Waldenström de rares cas de myélomes à IgM
E. Imagerie
- Scanner thoraco-abdomino-pelvien (20 % de maladie extra-médullaire)
- au diagnostic
- au suivi si atteinte extra-médullaire initiale ou suspectée lors de l’évolution
- Pas de place à l’IRM
- TEP : pas de place en routine, uniquement si suspicion de transformation en lymphome de haut grade
F. Fond d’oeil
Si suspicion de syndrome d’hyperviscosité
Systématique si Pic > 30 g/L
[table id =4 /]